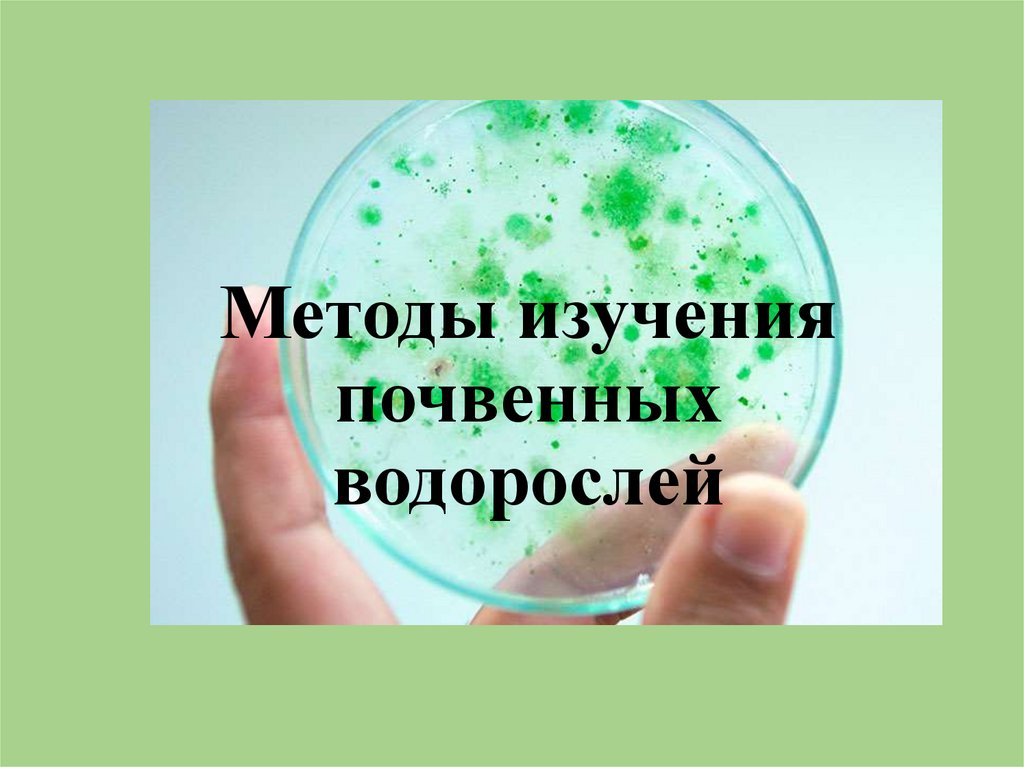

Похожие презентации:
Методы изучения почвенных водорослей
1.
Методы изученияпочвенных
водорослей
2.
Сбор почвенных проб. На выбранном для сбора проб участкеописываются растительность, рельеф местности, тип почвы. Если
имеются макроскопически заметные поверхностные разрастания
водорослей в виде позеленения почвы, корочек, пленок, собирают
поверхностный слой площадью 10 – 100 см3.
Для выявления водорослей в толще целинной почвы берут
индивидуальные пробы массой 20 – 50 г, приуроченные к определенным
растительным ассоциациям и к определенному почвенному горизонту.
В окультуренной почве берут средний образец массой 20 – 50 г,
составленный из 5 – 10 исходных.
Пробы берут стерильным ножом, совком или лопатой. В полевых
условиях стерилизация может быть проведена многократным втыканием
ножа в почву.
Образцы почв отбирают в конверты из плотной бумаги. На конверте
делается надпись простым карандашом: номер образца, дата сбора,
глубина взятия пробы.
3.
Почвенная культура со стекламиобрастания
Наиболее простым методом выявления видового
состава водорослей является метод «стекол
обрастания».
Исследуемую почву помещают в стерильные
чашки Петри, увлажняют дистиллированной
водой, если почва сухая. На поверхность почвы
раскладывают стерильные покровные стекла в
количестве 4 – 8 на чашку. Стерилизация
покровных стекол может быть проведена спиртом
или легким прокаливанием в пламени спиртовки.
Стекла положить так, чтобы между ними и почвой
оставались свободные пространства - «влажные
камеры». Через 5 – 7 дней можно начинать
просмотр стекол под микроскопом. Покровные
стекла снимают с поверхности почвы пинцетом,
удаляют крупные частички почвы и кладут на
предметное стекло в каплю воды. Стекла
просматривают не все одновременно, а
последовательно, с промежутками в 7-10 дней.
Для полного выявления видового состава
водорослей в почве достаточно 3 -6 недель
культивирования. Метод «стекол обрастания»
дает возможность выявить активную альгофлору,
выявить виды – виды доминанты, и видовой
состав водорослей.
4.
При просмотра стекол необходимо отличать водоросли от спор грибови от протонемы мхов.
Споры грибов имеют толстую оболочку и гомогенное содержимое.
Нити протонемы мхов отличаются от нитей водорослей косыми
перегородками и большим количеством хлоропластов в клетках.
5.
ОпределителиПри определении систематического
положения почвенных водорослей
обращают внимание на окраску,
форму клеток, строение нитей,
наличие или отсутствие слизистых
чехлов и капсул, форму хлоропласта.
Для определения почвенных
водорослей нет специального
определителя. Можно использовать
многотомный определитель
«Определитель пресноводных
водорослей СССР», определитель
«Пресноводные водоросли» Гуревича
А.А..
В ходе идентификации можно
изготавливать фотографии почвенных
водорослей.
6.
Водорослизагрязненной
почвы:
1, 2 - зеленая водоросль
Prasiola сrispa. 3 синезеленая водоросль
Phormidium autumnale
7.
Водоросли показатели переувлажненияминеральных почв
1. Anabaena variabilis; 2.
Cylindroshermum stagnata; 3. Oscillatoria
limosa; 4. Oscillatoria spiendida;
5.Pseudanabaena galeata; 6.Closterium
pusillium; 7. Cosmarium cubcrenatum; 8.
Cosmarium cucurbita;
9. Mesotaenium macrococcum; 10.
Cylindrocystis hrebissoni; 11.
Cylindrocystis crassa; 12. Tetraedron
minimum.
8.
Викторина «Почвенные водоросли»1. Из каких группировок состоят почвенные водоросли?
2. Какие преимущества, как биоиндикаторы, имеют
почвенные водоросли?
3. Сколько видов микроскопических почвенных
водорослей известно?
4. Как называется наука изучающая водоросли?
5. Какие приспособления имеют водоросли для жизни в
почве и на ее поверхности?
6. Какую роль в почвообразовательных процессах
играют почвенные водоросли?
7. Как нужно отбирать пробы почвенных водорослей
для исследования?
8. Какую возможность для исследователя дает метод
«стекол обрастания»?
9. Как при микроскопировании можно отличить
водоросли от спор грибов и протонемы мхов.

Биология
Биология








